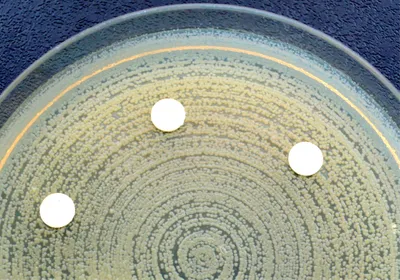
A petri dish with multidrug resistant bacterial colonies. A petri dish with multidrug resistant bacterial colonies.

bacterial infection
Trending

How a Forensic Biologist Exposed a DNA Lab Scandal That Shook Australia
After reviewing DNA evidence from a cold case murder, Kirsty Wright uncovered systemic flaws and deception in a forensics laboratory in Queensland, Australia.

Universe 25 Experiment
A series of rodent experiments showed that even with abundant food and water, personal space is essential to prevent societal collapse, but Universe 25's relevance to humans remains disputed.

Genetic Basis of Aneuploidy, Which Often Causes Pregnancy Loss, Revealed
Studying over 100,000 embryos revealed genetic factors behind chromosome segregation issues that lead to aneuploidy, informing future risk screening and intervention.

The Federal Government’s Research Innovation Lifeline Has Gone Dark
Congressional inaction has led to the expiration of the federal government’s SBIR/STTR program, cutting off a biotechnology lifeline.
Multimedia

Emerging Therapeutic Strategies in Oncology
In this symposium, scientists will highlight cutting-edge cancer treatments and the translational advances guiding their development.

Transitioning to 3D Cell Models for Better Insights
Phenotypic 3D cell models incorporate tissue architectures and extracellular matrices to recapitulate the complexity of the in vivo microenvironment.